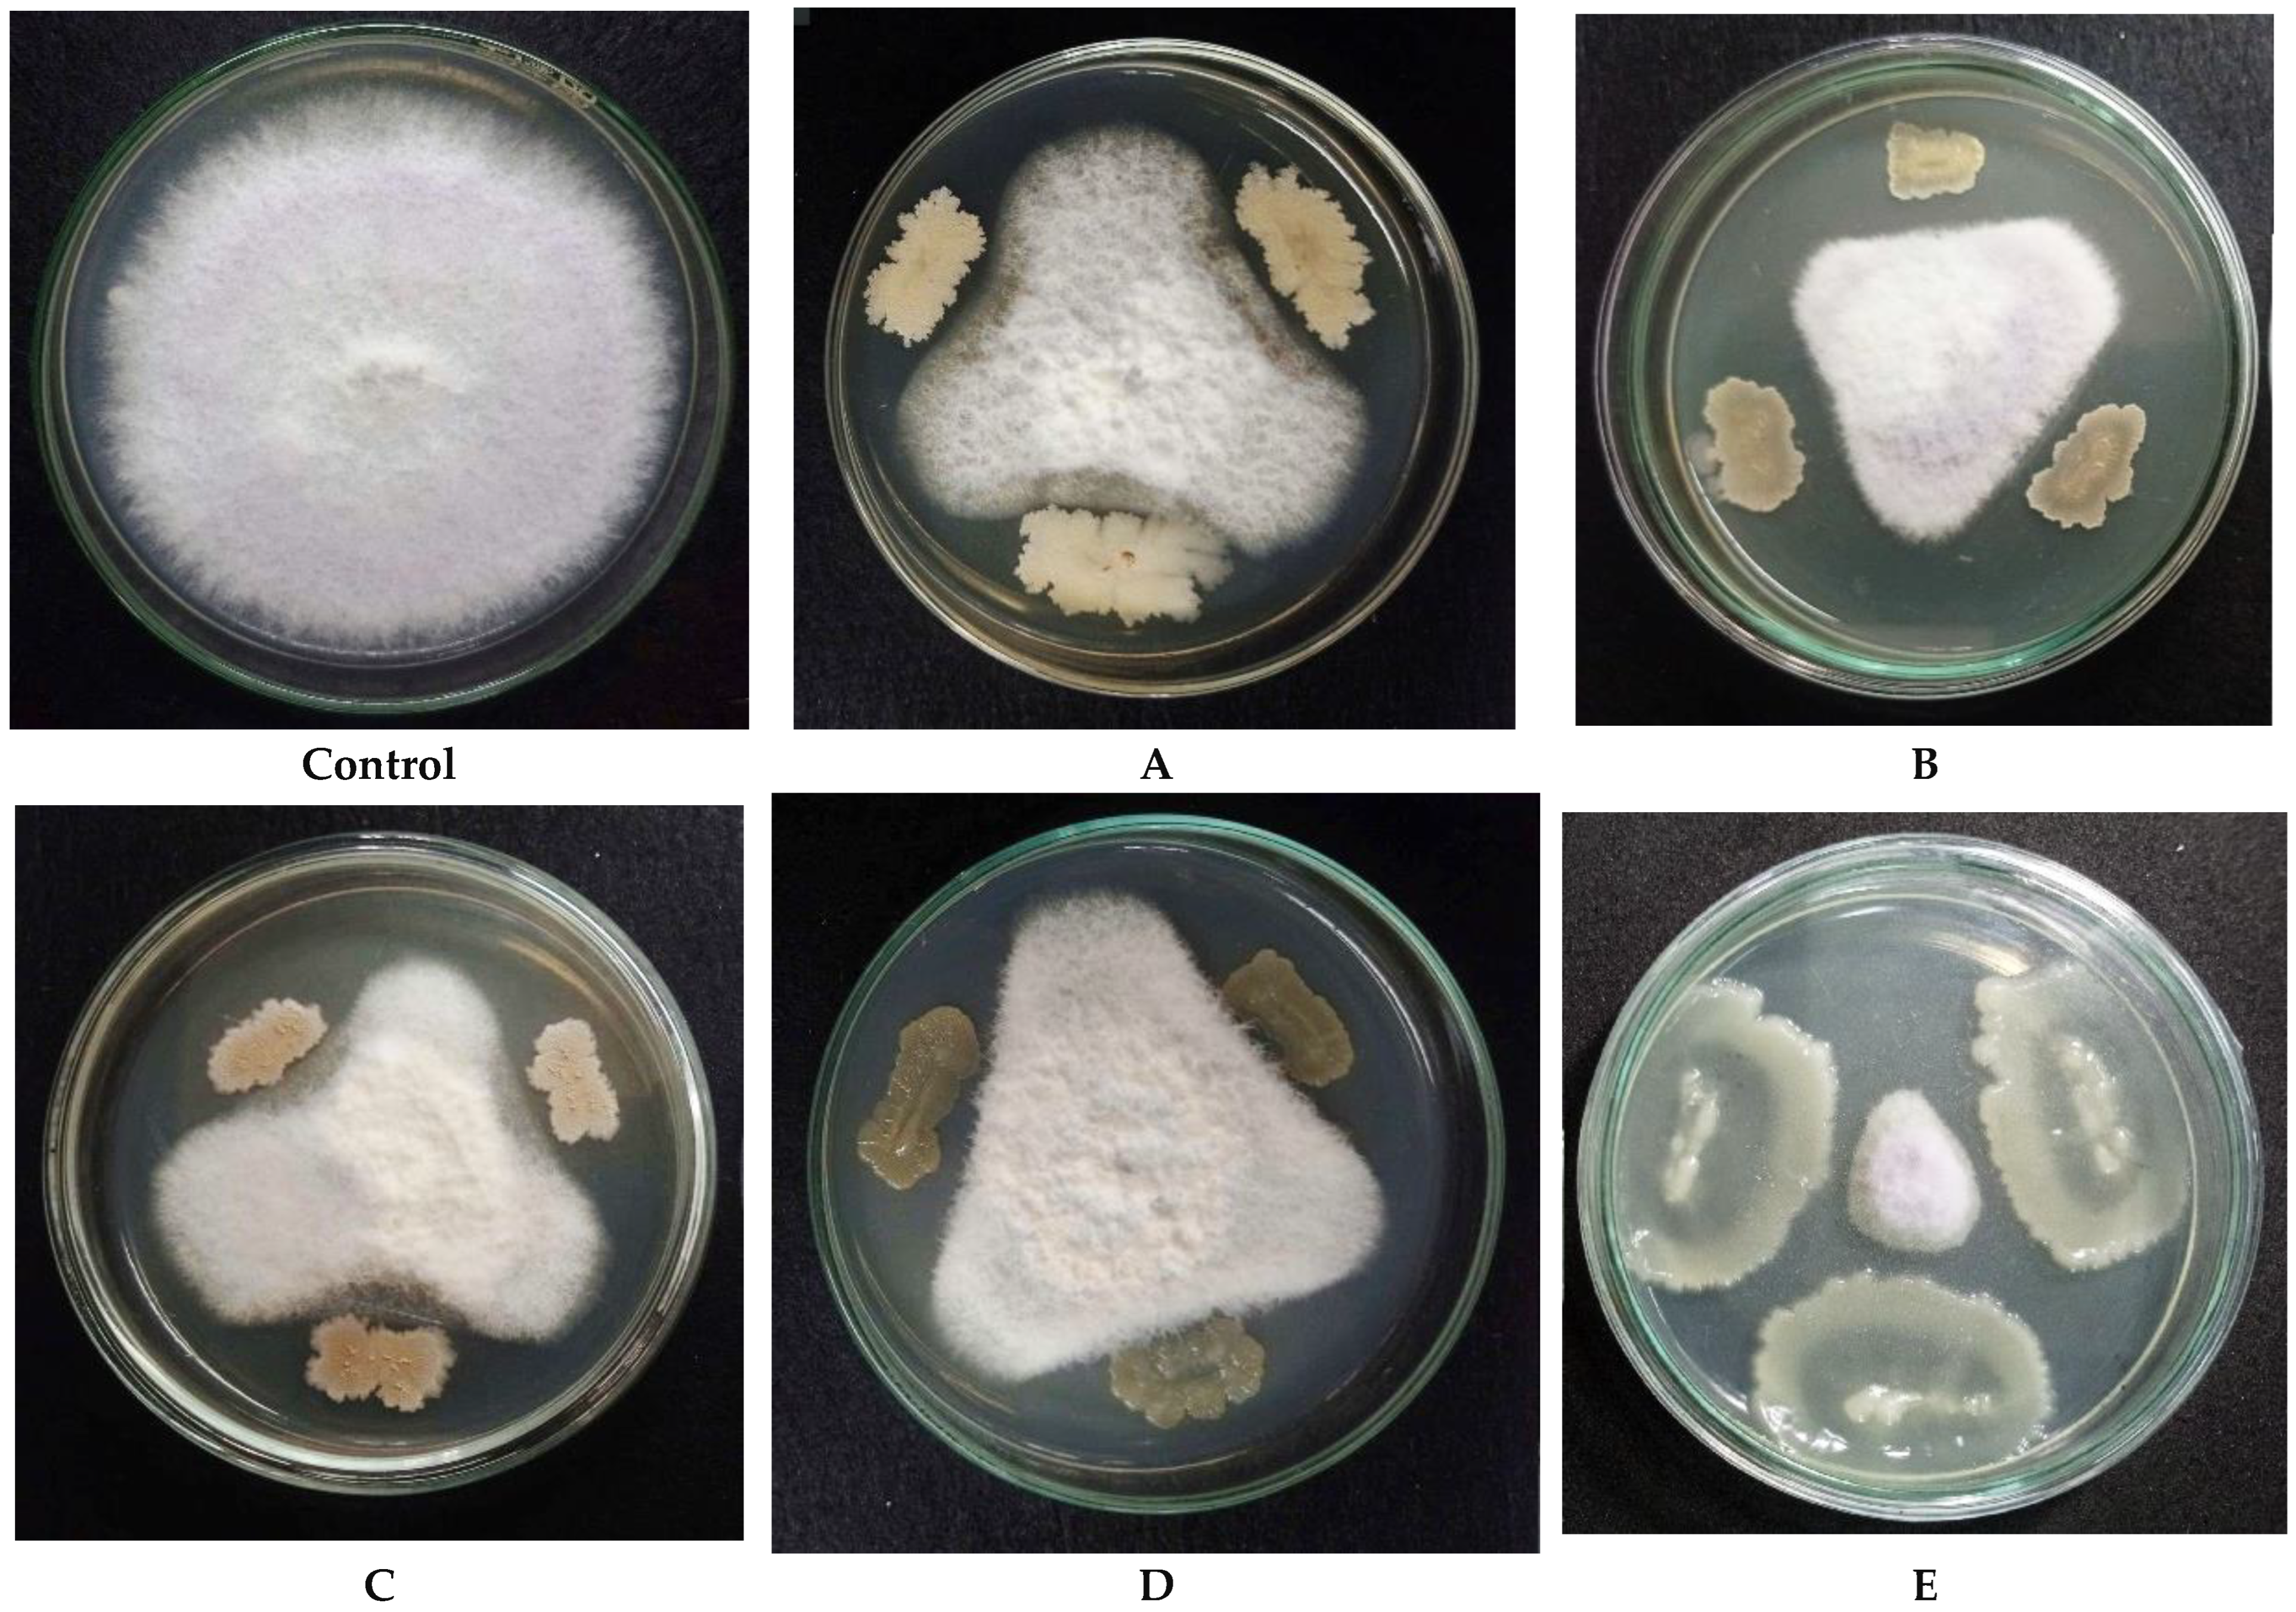

Eco-Friendly Biomass Production and Identification of Active Compounds of Paenibacillus polymyxa EB.KN35 with Potent Anti-Fusarium oxysporum Effect
Abstract
1. Introduction
2. Materials and Methods
2.1. Materials
2.2. Methods
2.2.1. Endophytic Bacterial Strains Screening
2.2.2. Method for Assessing Bacterial Density After Culture
2.2.3. Fermentation Optimization
- ♦ The effect of C/N sources on the growth of P. polymyxa EB.KN35
- ♦ The effect of agricultural processing byproducts (SPBPs) and LB ratio on the growth of P. polymyxa EB.KN35
- ♦ The effect of C/N source concentration on the growth of P. polymyxa EB.KN35
- ♦ The effect of mineral salts on the growth of P. polymyxa EB.KN35
- ♦ The effect of some fermentation condition parameters on the growth of P. polymyxa EB.KN35
- ♦ Scaling up the biomass production of P. polymyxa EB.KN35 using a 14 L bioreactor system
2.2.4. Detection and Identification of Bioactive Compounds Biosynthesized by P. polymyxa EB.KN35
2.2.5. Molecular Docking and DFT Calculation
2.2.6. Statistical Analysis
3. Results and Discussion
3.1. Screening of Endophytic Bacterial Strains with Potent Fungicidal Efficacy Against Fusarium oxysporum
3.2. The Effects of the Substrate, Salt, and Some Fermentation Parameters on the Growth of P. polymyxa EB.KN35
3.2.1. The Effect of the Substrate Source on the Growth of P. polymyxa EB.KN35
3.2.2. The Effect of Mineral Salts and Some Fermentation Parameters
3.3. Scaling up Biomass Production of P. polymyxa EB.KN35 via Fermentation in a 14 L Bioreactor
3.4. The Bioactive Compounds Produced by P. polymyxa EB.KN35
3.5. Molecular Docking and DFT Analysis
3.6. Implications and Recommendations
4. Conclusions
Author Contributions
Funding
Institutional Review Board Statement
Informed Consent Statement
Data Availability Statement
Conflicts of Interest
Appendix A
| No. | Strain | Antifungal Activity (%) | No. | Strain | Antifungal Activity (%) |
|---|---|---|---|---|---|
| 1 | EB.CK1 | - | 56 | EB.KN27 | 17.44 |
| 2 | EB.CK2 | 48.72 | 57 | EB.KN28 | 48.72 |
| 3 | EB.CK3 | - | 58 | EB.KN29 | - |
| 4 | EB.CK4 | - | 59 | EB.KN30 | - |
| 5 | EB.CK5 | 28.21 | 60 | EB.KN31 | 28.97 |
| 6 | EB.CK6 | - | 61 | EB.KN32 | - |
| 7 | EB.CK7 | 10.26 | 62 | EB.KN33 | 34.87 |
| 8 | EB.CK8 | - | 63 | EB.KN34 | - |
| 9 | EB.CK9 | 50.83 | 64 | EB.KN35 | 79.58 |
| 10 | EB.CK10 | - | 65 | EB.KN36 | - |
| 11 | EB.CK11 | 43.59 | 66 | EB.KN37 | - |
| 12 | EB.CK12 | - | 67 | EB.KN38 | 32.31 |
| 13 | EB.CK13 | 27.69 | 68 | EB.KN39 | - |
| 14 | EB.CK14 | 48.97 | 69 | EB.KN40 | - |
| 15 | EB.CK15 | - | 70 | EB.KN41 | 48.97 |
| 16 | EB.CK16 | - | 71 | EB.KN42 | - |
| 17 | EB.CK17 | - | 72 | EB.KN43 | 48.46 |
| 18 | EB.CK18 | 42.31 | 73 | EB.KN44 | - |
| 19 | EB.CK19 | 47.69 | 74 | EB.KN45 | 11.79 |
| 20 | EB.CK20 | - | 75 | EB.KN46 | - |
| 21 | EB.CK21 | 48.72 | 76 | EB.KN47 | - |
| 22 | EB.CK22 | 23.59 | 77 | EB.EH1 | 42.31 |
| 23 | EB.CK23 | - | 78 | EB.EH2 | 41.79 |
| 24 | EB.CK24 | - | 79 | EB.EH3 | - |
| 25 | EB.CK25 | 39.74 | 80 | EB.EH4 | 23.59 |
| 26 | EB.CK26 | 34.62 | 81 | EB.EH5 | - |
| 27 | EB.CK27 | - | 82 | EB.EH6 | 40.77 |
| 28 | EB.CK28 | - | 83 | EB.EH7 | 46.92 |
| 29 | EB.CK29 | 32.05 | 84 | EB.EH8 | - |
| 30 | EB.KN1 | 21.28 | 85 | EB.EH9 | - |
| 31 | EB.KN2 | - | 86 | EB.EH10 | - |
| 32 | EB.KN3 | - | 87 | EB.EH11 | - |
| 33 | EB.KN4 | 48.72 | 88 | EB.EH12 | 44.36 |
| 34 | EB.KN5 | 41.28 | 89 | EB.EH13 | - |
| 35 | EB.KN6 | - | 90 | EB.EH14 | - |
| 36 | EB.KN7 | - | 91 | EB.EH15 | 19.49 |
| 37 | EB.KN8 | 8.97 | 92 | EB.EH16 | - |
| 38 | EB.KN9 | - | 93 | EB.EH17 | 45.90 |
| 39 | EB.KN10 | 51.25 | 94 | EB.EH18 | 56.67 |
| 40 | EB.KN11 | 37.44 | 95 | EB.EH19 | 48.97 |
| 41 | EB.KN12 | 31.28 | 96 | EB.EH20 | - |
| 42 | EB.KN13 | - | 97 | EB.EH21 | 49.23 |
| 43 | EB.KN14 | 48.72 | 98 | EB.EH22 | - |
| 44 | EB.KN15 | 48.97 | 99 | EB.EH23 | - |
| 45 | EB.KN16 | - | 100 | EB.EH24 | - |
| 46 | EB.KN17 | 16.92 | 101 | EB.EH25 | 37.44 |
| 47 | EB.KN18 | - | 102 | EB.EH26 | - |
| 48 | EB.KN19 | 36.67 | 103 | EB.EH27 | - |
| 49 | EB.KN20 | - | 104 | EB.EH28 | 22.82 |
| 50 | EB.KN21 | - | 105 | EB.EH29 | - |
| 51 | EB.KN22 | - | 106 | EB.EH30 | - |
| 52 | EB.KN23 | - | 107 | EB.EH31 | - |
| 53 | EB.KN24 | 49.23 | 108 | EB.EH32 | - |
| 54 | EB.KN25 | 31.28 | 109 | EB.EH33 | 48.46 |
| 55 | EB.KN26 | - | 110 | EB.EH34 | 55.83 |
References
- Flood, J. A review of Fusarium wilt of oil palm caused by Fusarium oxysporum f. sp. elaeidis. Phytopathology 2006, 96, 660–662. [Google Scholar]
- Dean, R.; Kan, J.A.L.V.; Pretorius, Z.A.; Hammond-Kosack, K.E.; Pietro, A.D.; Spanu, P.D.; Rudd, J.J.; Dickman, M.; Kahmann, R.; Ellis, J.; et al. The top 10 fungal pathogens in molecular plant pathology. Mol. Plant Pathol. 2012, 13, 414–430. [Google Scholar] [PubMed]
- Joshi, R. A review of Fusarium oxysporum on its plant interaction and industrial use. J. Med. Plants Stud. 2018, 6, 112–115. [Google Scholar] [CrossRef]
- Nelson, P.E.; Toussoun, T.A.; Cook, R.J. Fusarium: Diseases, Biology and Taxonomy, 1st ed.; The Pennsylvania State University Press: London, UK, 1981. [Google Scholar]
- Rahman, M.Z.; Ahmad, K.; Kutawa, A.B.; Siddiqui, Y.; Saad, N.; Hun, T.G.; Hata, E.M.; Hossain, M.I. Biology, Diversity, Detection and Management of Fusarium oxysporum f. sp. niveum Causing Vascular Wilt Disease of Watermelon (Citrullus lanatus): A Review. Agronomy 2021, 11, 1310. [Google Scholar] [CrossRef]
- Lambel, S.; Lanini, B.; Vivoda, E.; Fauve, J.; Wechter, W.P.; Harris-Shultz, K.R.; Massey, L.; Levi, A. A major QTL associated with Fusarium oxysporum race a resistance identified in genetic populations derived from closely related watermelon lines using selective genotyping and genotyping-by-sequencing for SNP discovery. Theor. Appl. Genet. 2014, 127, 2105–2115. [Google Scholar]
- Thanassoulopoulos, C.C.; Giannopolitis, C.N.; Kitsos, G.T. Control of Fusarium wilt of Tomato and Watermelon with benomyl. Plant Dis. Rep. 1970, 54, 561–564. [Google Scholar]
- Hamed, E.R.; Abdel-Sayed, M.H.F.; Shehata, H.S. Suppression of Fusarium wilt of watermelon by biological and chemical control. J. Appl. Sci. Res. 2009, 5, 1816–1825. [Google Scholar]
- Miller, N.F.; Standish, J.R.; Quesada-Ocampo, L.M. Sensitivity of Fusarium oxysporum f. sp. niveum to Prothioconazole and Pydiflumetofen in Vitro and Efficacy for Fusarium Wilt Management in Watermelon. Plant Health Prog. 2020, 21, 13–18. [Google Scholar]
- Zhang, M.; Li, J.; Shen, A.; Tan, S.; Yan, Z.; Yu, Y.; Xue, Z.; Tan, T.; Zeng, L. Isolation and Identification of Bacillus amyloliquefaciens IBFCBF-1 with Potential for Biological Control of Phytophthora Blight and Growth Promotion of Pepper. J. Phytopathol. 2016, 164, 1012–1021. [Google Scholar]
- Siddiqui, Z.A. PGPR: Biocontrol and Biofertilization, 1st ed.; Springer: Dordrecht, The Netherlands, 2006; pp. 111–142. [Google Scholar]
- Tian, H.; Riggs, R.D. Effects of rhizobacteria on soybean cyst nematodes, Heterodera glycines. J. Nematol. 2000, 32, 377–388. [Google Scholar]
- Nadarajah, K.; Rahman, N.S.N.A. The Microbial Connection to Sustainable Agriculture. Plants 2023, 12, 2307. [Google Scholar] [CrossRef] [PubMed]
- Prasad, M.; Chaudhary, M.; Choudhary, M.; Kumar, T.K.; Jat, L.K. Plant-soil-microbe nexus. In Agriculturally Important Microbes for Sustainable Agriculture, 1st ed.; Meena, V.S., Mishra, P.K., Bisht, J.K., Pattanayak, A., Eds.; Springer Nature: Singapore, 2017; Volume 1, pp. 31–49. [Google Scholar]
- Ryu, C.-M.; Kim, J.; Choi, O.; Park, S.-Y.; Park, S.-H.; Park, C.S. Nature of a root-associated Paenibacillus polymyxa from field-grown winter barley in Korea. J. Microbiol. Biotechnol. 2005, 15, 984–991. [Google Scholar]
- Ryu, C.-M.; Kim, J.; Choi, O.; Kim, S.H.; Park, C.S. Improvement of biological control capacity of Paenibacillus polymyxa E681 by seed pelleting on sesame. Biol. Control 2006, 39, 282–289. [Google Scholar] [CrossRef]
- Raza, W.; Makeen, K.; Wang, Y.; Xu, Y.; Qirong, S. Optimization, purification, characterization and antioxidant activity of an extracellular polysaccharide produced by Paenibacillus polymyxa SQR-21. Bioresour. Technol. 2011, 102, 6095–6103. [Google Scholar] [CrossRef]
- Mei, L.; Liang, Y.; Zhang, L.; Wang, Y.; Guo, Y. Induced systemic resistance and growth promotion in tomatoby an indole-3-acetic acid-producing strain of Paenibacillus polymyxa. Ann. Appl. Biol. 2014, 165, 270–279. [Google Scholar] [CrossRef]
- Raza, W.; Yuan, J.; Ling, N.; Huang, Q.; Shen, Q. Production of volatile organic compounds by an antagonistic strain Paenibacillus polymyxa WR-2 in the presence of root exudates and organic fertilizer and their antifungal activity against Fusarium oxysporum f. sp. niveum. Biol. Control 2015, 80, 89–95. [Google Scholar] [CrossRef]
- Shi, L.; Du, N.; Shu, S.; Sun, J.; Li, S.; Guo, S. Paenibacillus polymyxa NSY50 suppresses Fusarium wilt in cucumbers by regulating the rhizospheric microbial community. Sci. Rep. 2017, 7, 41234. [Google Scholar] [CrossRef]
- Naoufal, D.; Ilham, B.; Amine, H.; Khadija, O. Isolation and Characterisation of Endophytic Strain Paenibacillus polymyxa SR19 from Urtica Dioica and the Study of Their Effect Against Fusarium Oxysporum F. Sp Tomato. Ann. Res. Rev. Biol. 2018, 29, 1–8. [Google Scholar] [CrossRef]
- Zhai, Y.; Zhu, J.-X.; Tan, T.-M.; Xu, J.-P.; Shen, A.-R.; Yang, X.-B.; Li, J.-L.; Zeng, L.-B.; Wei, L. Isolation and characterization of antagonistic Paenibacillus polymyxa HX-140 and its biocontrol potential against Fusarium wilt of cucumber seedlings. BMC Microbiol. 2021, 21, 75. [Google Scholar] [CrossRef]
- Cai, F.; Yang, C.; Ma, T.; Osei, R.; Jin, M.; Zhang, C.; Wang, Y. An endophytic Paenibacillus polymyxa hg18 and its biocontrol potential against Fusarium oxysporum f. sp. cucumerinum. Biol. Control 2024, 188, 105380. [Google Scholar] [CrossRef]
- Yang, F.; Jiang, H.; Ma, K.; Hegazy, A.; Wang, X.; Liang, S.; Chang, G.; Yu, L.; Tian, B.; Shi, X. Genomic and phenotypic analyses reveal Paenibacillus polymyxa PJH16 is a potential biocontrol agent against cucumber fusarium wilt. Microbe Virus Interact. Plants 2024, 188, 105380. [Google Scholar] [CrossRef] [PubMed]
- Gong, X.-Y.; Luan, Z.-K.; Pei, Y.-S.; Wang, S.-G. Culture conditions for flocculant production by Paenibacillus polymyxa BY-28. J. Environ. Sci. Health A Tox. Hazard. Subst. Environ. Eng. 2003, 38, 657–669. [Google Scholar] [PubMed]
- Kim, S.; Bang, J.; Kim, H.; Beuchat, L.R.; Ryu, J.-H. Inactivation of Escherichia coli O157:H7 on stainless steel upon exposure to Paenibacillus polymyxa biofilms. Int. J. Food Microbiol. 2013, 167, 328–336. [Google Scholar] [PubMed]
- Niu, B.; Vater, J.; Rueckert, C.; Blom, J.; Lehmann, M.; Ru, J.-J.; Chen, X.-H.; Wang, Q.; Borriss, R. Polymyxin P is the active principle in suppressing phytopathogenic Erwinia spp. by the biocontrol rhizobacterium Paenibacillus polymyxa M-1. BMC Microbiol. 2013, 13, 137. [Google Scholar]
- Yang, S.; Kim, S.; Ryu, J.-H.; Kim, H. Inhibitory activity of Paenibacillus polymyxa on the biofilm formation of Cronobacter spp. on stainless steel surfaces. J. Food Sci. 2013, 78, M1036–M1040. [Google Scholar]
- Xu, S.; Bai, Z.; Jin, B.; Xiao, R.; Zhuang, G. Bioconversion of wastewater from sweet potato starch production to Paenibacillus polymyxa biofertilizer for tea plants. Sci. Rep. 2014, 28, 4131. [Google Scholar] [CrossRef]
- Kim, Y.S.; Kotnala, B.; Kim, Y.H.; Jeon, Y. Biological characteristics of Paenibacillus polymyxa GBR-1 involved in root rot of stored Korean ginseng. J. Ginseng Res. 2016, 40, 453–461. [Google Scholar]
- Zhao, G.; Niu, M.; Lu, S.; Guan, J. Cultivation of Paenibacillus polymyxa by solid-state fermentation of pear residues. Trans. Chin. Soc. Agric. Eng. 2016, 32, 303–308. [Google Scholar]
- Gao, Y.; Liang, J.; Xiao, R.; Zang, P.; Zhao, Y.; Zhang, L. Effect of four trace elements on Paenibacillus polymyxa Pp-7250 proliferation, activity and colonization in ginseng. AMB Express 2018, 8, 164. [Google Scholar]
- Nasran, H.S.; Yusof, H.M.; Halim, M.; Rahman, N.A.A. Optimization of Protective Agents for The Freeze-Drying of Paenibacillus polymyxa Kp10 as a Potential Biofungicide. Molecules 2020, 25, 2618. [Google Scholar] [CrossRef]
- Kaziūnienė, J.; Mažylytė, R.; Krasauskas, A.; Toleikienė, M.; Gegeckas, A. Paenibacillus Polymyxa MVY-024: Plant Growth Promoting Bacteria Which is Easy to Apply on an Industrial Scale. Res. Sq. 2021. [Google Scholar] [CrossRef]
- Pham, T.H.; Tran, D.L.; Le, T.T.; Vu, T.T.; Nguyen, T.P.T.; Ho, T.C.; Vu, D.H.; Le, D.Q. Optimization of fermentation medium for spore production of Paenibacillus polymyxa IN937a and its antifungal activity. Vietnam J. Biotechnol. 2022, 20, 117–124. [Google Scholar]
- Rypniewski, W.R.; Dambmann, C.; von der Osten, C.; Dauter, M.; Wilson, K.S. Structure of inhibited trypsin from Fusarium oxysporum at 1.55 A. Acta Crystallogr. D Biol. Crystallogr. 1995, 51, 73–85. [Google Scholar]
- Chandrasekaran, M.; Thangavelu, B.; Chun, S.C.; Sathiyabama, M. Proteases from phytopathogenic fungi and their importance in phytopathogenicity. J. Gen. Plant Pathol. 2016, 82, 233–239. [Google Scholar]
- Dubovenko, A.G.; Dunaevsky, Y.E.; Belozersky, M.A.; Oppert, B.; Lord, J.C.; Elpidina, E.N. Trypsin-like proteins of the fungi as possible markers of pathogenicity. Fungal Biol. 2010, 114, 151–159. [Google Scholar]
- Ngo, V.A.; Wang, S.L.; Nguyen, V.B.; Doan, C.T.; Tran, T.N.; Tran, D.M.; Tran, T.D.; Nguyen, A.D. Phytophthora Antagonism of Endophytic Bacteria Isolated from Roots of Black Pepper (Piper nigrum L.). Agronomy 2020, 10, 286. [Google Scholar] [CrossRef]
- Mai, K.H.; Dinh, T.K.N.; Vuong, T.H. Practice Microbiology, 1st ed.; Pedagogical University Publisher: Hanoi, Vietnam, 2011; pp. 57–58. [Google Scholar]
- Nguyen, D.N.; Wang, S.-L.; Nguyen, A.D.; Doan, M.D.; Tran, D.M.; Nguyen, T.H.; Ngo, V.A.; Doan, C.T.; Tran, T.N.; Do, V.C.; et al. Potential Application of Rhizobacteria Isolated from the Central Highland of Vietnam as an Effective Biocontrol Agent of Robusta Coffee Nematodes and as a Bio-Fertilizer. Agronomy 2021, 11, 1887. [Google Scholar] [CrossRef]
- Nguyen, T.H.; Wang, S.-L.; Nguyen, A.D.; Doan, M.D.; Tran, D.M.; Tran, T.N.; Doan, C.T.; Nguyen, V.B. Novel α-Amylase Inhibitor Hemi-Pyocyanin Produced by Microbial Conversion of Chitinous Discards. Mar. Drugs 2022, 20, 283. [Google Scholar] [CrossRef]
- Azmi, A.F.M.; Adli, D.N.; Hassim, H.A. Effects of Adding Soybean Waste on Growth Performance and Carcass Quality in Quails. Adv. Anim. Vet. Sci. 2023, 11, 1307–1312. [Google Scholar]
- Liang, T.W.; Lee, Y.C.; Wang, S.L. Tyrosinase inhibitory activity of supernatant and semi-purified extracts from squid pen fermented with Burkholderia cepacia TKU025. Res. Chem. Intermed. 2015, 41, 6105–6116. [Google Scholar]
- Wang, S.-L.; Yu, H.-T.; Tsai, M.-H.; Doan, C.T.; Nguyen, V.B.; Do, V.C.; Nguyen, A.D. Conversion of squid pens to chitosanases and dye adsorbents via Bacillus cereus. Res. Chem. Intermed. 2018, 44, 4903–4911. [Google Scholar] [CrossRef]
- Zhao, X.; Zhou, J.; Tian, R.; Liu, Y. Microbial volatile organic compounds: Antifungal mechanisms, applications, and challenges. Food Microbiol. 2022, 13, 922450. [Google Scholar] [CrossRef] [PubMed]
- Rani, A.; Rana, A.; Dhaka, R.K.; Singh, A.P.; Chahar, M.; Singh, S.; Nain, L.; Singh, K.P.; Minz, D. Bacterial volatile organic compounds as biopesticides, growth promoters and plant-defense elicitors: Current understanding and future scope. Biotechnol. Adv. 2023, 63, 108078. [Google Scholar] [CrossRef] [PubMed]
- Insam, H.; Seewald, M.S.A. Volatile organic compounds (VOCs) in soils. Biol. Fertil. Soils 2010, 46, 199–213. [Google Scholar] [CrossRef]
- Tokmakova, L.M.; Shevchenko, L.A.; Trepach, A.O. Paenibacillus Polymyxa КB—Producer of Biologically Active Substances. Agric. Microbiol. 2022, 35, 42–57. [Google Scholar]
- Khan, M.S.; Gao, J.; Chen, X.; Zhang, M.; Yang, F.; Du, Y.; Moe, T.S.; Munir, I.; Xue, J.; Zhang, X. Isolation and Characterization of Plant Growth-Promoting Endophytic Bacteria Paenibacillus polymyxa SK1 from Lilium lancifolium. Biomed. Res. Int. 2020, 2020, 8650957. [Google Scholar] [CrossRef]
- Sun, H.; Zhang, J.; Liu, W.; Wenhui, E.; Wang, X.; Li, H.; Cui, Y.; Zhao, D.; Liu, K.; Du, B.; et al. Identification and combinatorial engineering of indole-3-acetic acid synthetic pathways in Paenibacillus polymyxa. Biotechnol. Biofuels Bioprod. 2022, 15, 81. [Google Scholar] [CrossRef]
- Li, X.; Ma, S.; Meng, Y.; Wei, W.; Peng, C.; Ling, C.; Fan, S.; Liu, Z. Characterization of Antagonistic Bacteria Paenibacillus polymyxa ZYPP18 and the Effects on Plant Growth. Plants 2023, 12, 2504. [Google Scholar] [CrossRef]
- Ryu, C.M.; Farag, M.A.; Hu, C.H.; Reddy, M.S.; Wei, H.X.; Paré, P.W.; Kloepper, J.W. Bacterial volatiles promote growth in Arabidopsis. Proc. Natl. Acad. Sci. USA 2003, 100, 4927–4932. [Google Scholar] [CrossRef]
- Farag, M.A.; Ryu, C.M.; Sumner, L.W.; Paré, P.W. GC-MS SPME profiling of rhizobacterial volatiles reveals prospective inducers of growth promotion and induced systemic resistance in plants. Phytochemistry 2006, 67, 2262–2268. [Google Scholar] [CrossRef]
- Fernando, W.G.D.; Ramarathnam, R.; Krishnamoorthy, A.S.; Savchuk, S.C. Identification and use of potential bacterial organic antifungal volatiles in biocontrol. Soil Biol. Biochem. 2005, 37, 955–964. [Google Scholar]
- Schulz, S.; Dickschat, J.S. Bacterial volatiles: The smell of small organisms. Nat. Prod. Rep. 2007, 24, 814–842. [Google Scholar] [PubMed]
- Ngo, V.A.; Wang, S.-L.; Nguyen, V.B.; Phan, T.Q.; Tran, T.H.T.; Doan, M.D.; Nguyen, D.S.; Nguyen, A.D. Utilization of shrimp heads for scaling up of production of Bacillus velezensis EB.KN15, its bioactive compounds and novel anti-fungal effect against durian pathogen fungi. Res. Chem. Intermed. 2024, 50, 5061–5080. [Google Scholar] [CrossRef]
- Cheng, W.; Yang, J.; Nie, Q.; Huang, D.; Yu, C.; Zheng, L.; Cai, M.; Thomashow, L.S.; Weller, D.M.; Yu, Z.; et al. Volatile organic compounds from Paenibacillus polymyxa KM2501-1 control Meloidogyne incognita by multiple strategies. Sci. Rep. 2017, 7, 16213. [Google Scholar] [CrossRef]
- Song, W.; Dai, M.; Gao, S.; Mi, Y.; Zhang, S.; Wei, J.; Zhao, H.; Duan, F.; Liang, C.; Shi, Q. Volatile organic compounds produced by Paenibacillus polymyxa J2-4 exhibit toxic activity against Meloidogyne incognita. Pest. Manag. Sci. 2024, 80, 1289–1299. [Google Scholar]
- Daria, R.; Ute, R.-W.; Tomislav, C.; Angelika, S.; Maria, S.; Gabriele, B. Aerial Warfare: A Volatile Dialogue between the Plant Pathogen Verticillium longisporum and Its Antagonist Paenibacillus polymyxa. Front. Plant Sci. 2017, 8, 1294. [Google Scholar]
- Jinbin, W.; Jin, Z.; Meng, S.; Hao, W.; Min, Z.; Hongyan, Y. Biocontrol mechanisms of Bacillus velezensis against Fusarium oxysporum from Panax ginseng. Biol. Control 2023, 182, 105222. [Google Scholar]
- Sun, L.; Wang, W.; Zhang, X.; Gao, Z.; Cai, S.; Wang, S.; Li, Y. Bacillus velezensis BVE7 as a promising agent for biocontrol of soybean root rot caused by Fusarium oxysporum. Front. Microbiol. 2023, 14, 1275986. [Google Scholar]
- Dong, H.; Gao, R.; Dong, Y.; Yao, Q.; Zhu, H. Bacillus velezensis RC116 Inhibits the Pathogens of Bacterial Wilt and Fusarium Wilt in Tomato with Multiple Biocontrol Traits. Int. J. Mol. Sci. 2023, 24, 8527. [Google Scholar] [CrossRef]
- Myo, E.M.; Liu, B.; Ma, J.; Shi, L.; Jiang, M.; Zhang, K.; Ge, B. Evaluation of Bacillus velezensis NKG-2 for bio-control activities against fungal diseases and potential plant growth promotion. Biol. Control 2019, 134, 23–31. [Google Scholar]
- Vu, T.T.L.; Wang, S.L.; Ho, T.T.T.; Luc, Q.T.; Phan, T.Q.; Phan, T.K.T.; Dam, T.B.H.; Phan, T.K.P.; Nguyen, A.D.; Nguyen, V.B. Elucidation of potent mammalian enzymes inhibitors targeting anti-diabetes drug from Castanea mollissima blume, 1851: An edible herbal collected in Vietnam via experimental and computation approaching. Res. Chem. Intermed. 2024, 50, 6065–6086. [Google Scholar]

| Strain | Origin | Biocontrol | Antifungal Effect (%) | Ref. |
|---|---|---|---|---|
| P. polymyxa EB.KN35 | Root of the durian plant | F. oxysporum | 79.58 | This study |
| P. polymyxa SQR-21 | Rhizosphere of healthy watermelon plants | F. oxysporum | 70 | [17] |
| P. polymyxa CF05 | Cryptomeria fortunei | F. oxysporum f. sp. lycoersici | 78.24 | [18] |
| P. polymyxa WR-2 | - | F. oxysporum f. sp. niveum | 36–40 | [19] |
| P. polymyxa NSY50 | Vinegar waste compost | F. oxysporum f. sp. cucumerinum | [20] | |
| P. polymyxa SR19 | Root of the Urtica dioica plant | F. oxysporum | ≥60 | [21] |
| P. polymyxa HX-140 | Rhizosphere soil of rape | F. oxysporum f. sp. cucumerinum | 55.6 | [22] |
| P. polymyxa hg18 | Healthy cucumber plant | F. oxysporum f. sp. cucumerinum | 69.57 | [23] |
| P. polymyxa PJH16 | Cucumber soil | F. oxysporum f. sp. cucumerinum Foc FJH36 | 88.36 | [24] |
| No. | RT (min) | Area (%) | Compounds |
|---|---|---|---|
| 1 | 5.23 | 0.21 | Metanephrine |
| 2 | 7.94 | 0.48 | Glafenin |
| 3 | 11.22 | 0.2 | Bexarotene |
| 4 | 26.01 | 0.05 | Cyclopenta[b]pyran-5-octanoic acid, octahydro-ε,2,6-trioxo-, (4aR,5R,7aS)- |
| 5 | 26.71 | 0.05 | Tetranorprostaglandin J2 |
| 6 | 28.71 | 0.05 | N-butyryl-DL-homoserine lactone |
| 7 | 36.66 | 0.04 | Epitestosterone |
| 8 | 38.17 | 0.03 | Crinan-11-ol, 1,2-didehydro-3-methoxy-, (3β,5α,11S,13β,19α)- (CAS) |
| 9 | 38.67 | 77.58 | Glycine, N-2-naphthalenyl-, 2-[(3,5-dibromo-2,4-dihydroxyphenyl)methylene]hydrazide |
| 10 | 39.59 | 9.87 | Cholestan-3-ol, 4-methyl-, (3β,4α,5α)- |
| 11 | 44.62 | 5.01 | Estra-1,3,5(10)-trien-17-one, 3-hydroxy-, O-methyloxime (CAS) |
| Site No. | Size | Residues |
|---|---|---|
| 1 | 27 | Ala24, Gly25, Asp26, Phe27, Pro28, Ser70, Leu71, Ser72, Gly116, Asn117, Asn154 |
| 2 | 24 | Asp129, Pro130, Val131, Ala132, Ile162, Val163, Ser164, Arg165, Cys168, Met180, Phe181, Cys182, |
| 3 | 16 | Pro130, Val131, Ser134, Ser135, Ala136, Ile162, Asp201, Ser201a, Ile210 |
| 4 | 15 | Asp26, Phe27, Pro28, Phe29, Thr137, Lys157, Val200, Asp201, Asn203 |
| Ligands | Symbol of the L–P Complex | Binding Site | RMSD (Å) | DS (kcal/mol) | Linkages | Interactions (Distance (Å)/E (kcal/mol) / Linkage Type) |
|---|---|---|---|---|---|---|
| 1 | 1-1TRY | 2 | 1.36 | −9.5 | 4 (1 H-acceptor, 3 pi-H) | Arg165 (3.06/−2.4/H-acceptor) Val131 (4.44/−0.6/pi-H) Val131 (4.69/−1.0/pi-H) Ala132 (4.69/−1.0/pi-H) |
| 2 | 2-1TRY | 2 | 1.82 | −9.6 | 5 (2 H-donor, 1 H-acceptor, 2 pi-H) | Pro130 (3.32/−1.0/H-donor) Cys182 (3.14/−1.1/H-donor) Cys182 (3.21/−0.4/H-acceptor) Asp129 (4.46/−0.8/pi-H) Val131 (4.78/−0.6/pi-H) |
| 3 | 3-1TRY | 1 | 1.21 | −9.0 | 2 (1 H-donor, 1 pi-H) | Ser70 (2.96/−0.9/H-donor) Ser75 (3.96/−1.2/pi-H) |
| 4 | 4-1TRY | 1 | 0.87 | −9.4 | 2 (1 H-donor, 1 H-acceptor) | Gly116 (3.04/−1.5/H-donor) Leu71 (3.21/−2.0/H-acceptor) |
| 5 | 5-1TRY | 2 | 1.80 | −9.1 | 5 (3 H-donor, 2 H-acceptor) | Asp129 (3.04/−1.4/H-donor) Pro130 (2.83/−1.3/H-donor) Asp129 (3.12/−5.0/H-donor) Ala132 (3.29/−0.6/H-acceptor) Arg165 (2.95/−3.1/H-acceptor) |
| 6 | 6-1TRY | 2 | 1.86 | −7.86 | 2 (1 H-donor, 1 pi-H) | Asp129 (2.94/−4.3/H-donor) Ala132 (3.02/−2.9/H-acceptor) |
| 7 | 7-1TRY | 2 | 1.66 | −8.7 | 1 H-donor | Try120 (3.37/−0.5/H-donor) |
| 8 | 8-1TRY | 1 | 1.90 | −8.5 | 1 H-donor | Asn117 (2.95/−0.6/H-donor) |
| 9 | 9-1TRY | 1 | 1.95 | −10.6 | 1 H-donor | Asn154 (3.42/−0.8/H-donor) |
| 10 | 10-1TRY | 4 | 1.86 | −8.2 | 1 H-donor | Asp26 (3.13/−0.6/H-donor) |
| 11 | 11-1TRY | 4 | 1.47 | −7.6 | H-pi | Phe27 (4.21/−0.7/H-pi) |
| AS | AS-1TRY | 1 | 1.81 | −9.4 | 1 H-acceptor | Gly25 (3.15/−1.9/H-acceptor) |
Disclaimer/Publisher’s Note: The statements, opinions and data contained in all publications are solely those of the individual author(s) and contributor(s) and not of MDPI and/or the editor(s). MDPI and/or the editor(s) disclaim responsibility for any injury to people or property resulting from any ideas, methods, instructions or products referred to in the content. |
© 2025 by the authors. Licensee MDPI, Basel, Switzerland. This article is an open access article distributed under the terms and conditions of the Creative Commons Attribution (CC BY) license (https://creativecommons.org/licenses/by/4.0/).
Share and Cite
Ngo, V.A.; Nguyen, A.D.; Wang, S.-L.; Phan, T.Q.; Tran, T.H.T.; Nguyen, D.S.; Nguyen, V.B. Eco-Friendly Biomass Production and Identification of Active Compounds of Paenibacillus polymyxa EB.KN35 with Potent Anti-Fusarium oxysporum Effect. Microorganisms 2025, 13, 800. https://doi.org/10.3390/microorganisms13040800
Ngo VA, Nguyen AD, Wang S-L, Phan TQ, Tran THT, Nguyen DS, Nguyen VB. Eco-Friendly Biomass Production and Identification of Active Compounds of Paenibacillus polymyxa EB.KN35 with Potent Anti-Fusarium oxysporum Effect. Microorganisms. 2025; 13(4):800. https://doi.org/10.3390/microorganisms13040800
Chicago/Turabian StyleNgo, Van Anh, Anh Dzung Nguyen, San-Lang Wang, Tu Quy Phan, Thi Ha Trang Tran, Dinh Sy Nguyen, and Van Bon Nguyen. 2025. "Eco-Friendly Biomass Production and Identification of Active Compounds of Paenibacillus polymyxa EB.KN35 with Potent Anti-Fusarium oxysporum Effect" Microorganisms 13, no. 4: 800. https://doi.org/10.3390/microorganisms13040800
APA StyleNgo, V. A., Nguyen, A. D., Wang, S.-L., Phan, T. Q., Tran, T. H. T., Nguyen, D. S., & Nguyen, V. B. (2025). Eco-Friendly Biomass Production and Identification of Active Compounds of Paenibacillus polymyxa EB.KN35 with Potent Anti-Fusarium oxysporum Effect. Microorganisms, 13(4), 800. https://doi.org/10.3390/microorganisms13040800

